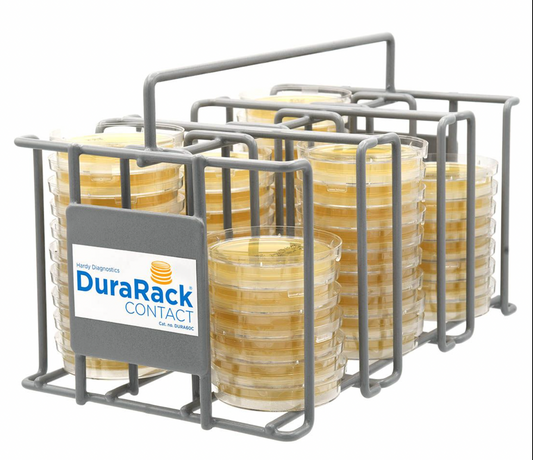
DuraRack®, Metal Contact Plate Rack, for 15x65mm Contact Plates, Holds 60 Plates

-
Hardy Diagnostics P365 Contact Plate – TSA with Lecithin & Tween, Gamma-Irradiated, 10/pack
Regular price $52.36 USDRegular priceUnit price / per -
Hardy Diagnostics P46 Contact Plate – SabDex w/ Lecithin & Tween 80, Non-Irradiated , 10/pack
Regular price $50.85 USDRegular priceUnit price / per -
Hardy Diagnostics P34 Contact Plate – TSA w/ Lecithin & Tween, USP 797, Non-Irradiated, 10 plates
Regular price $28.93 USDRegular priceUnit price / per -
Hardy Diagnostics W340 – SterEM™ TSA Settle Plate, Gamma-Irradiated, Triple-Bagged, 10/Pack
Regular price $48.85 USDRegular priceUnit price / per -
Hardy Diagnostics W385 – SterEM™ SabDex w/ Lecithin & Tween 80, Settle Plate, Gamma-Irradiated, Triple-Bagged), 10/pack
Regular price $72.40 USDRegular priceUnit price / per -
DuraRack®, Metal Contact Plate Rack, for 15x65mm Contact Plates, Holds 60 Plates
Regular price $186.68 USDRegular priceUnit price / per